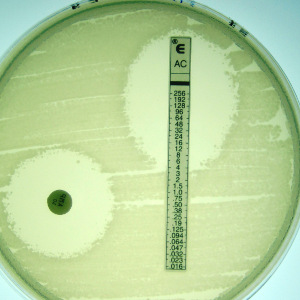

La biotech, des parcours possibles de la seconde à bac+8...
La biotechnologie propose une formation complète, de la seconde à la terminale au lycée, et de bac+2 à bac+8 dans l'enseignement supérieur.
Les biotechnologies sont l'enjeu central du XXIème siècle : procédés et applications de la biologie, les biotechnologies concernent notamment la santé, l'environnement, l'agroalimentaire... voir en bas de page.
Les études en biotechnologies forment donc à la fois des citoyens concernés par les questions brûlantes d'aujourd'hui et de demain, mais aussi les préparent à des métiers passionnants aux débouchés porteurs. Basées sur le concret, les études se font principalement au sein de laboratoires modernes.
Les biotechnologies sont l'enjeu central du XXIème siècle : procédés et applications de la biologie, les biotechnologies concernent notamment la santé, l'environnement, l'agroalimentaire... voir en bas de page.
Les études en biotechnologies forment donc à la fois des citoyens concernés par les questions brûlantes d'aujourd'hui et de demain, mais aussi les préparent à des métiers passionnants aux débouchés porteurs. Basées sur le concret, les études se font principalement au sein de laboratoires modernes.
Les enseignants de biotechnologie sont des professeurs certifiés ou agrégés qui interviennent :
- dans l'enseignement secondaire, au lycée général et technologique, en classes de
- seconde via les ETO (enseignements technologiques optionnels) de Sanitaire & Social, et de Biotechnologies
- première et terminale ST2S
- première et terminale STL
- dans l'enseignement supérieur, en
- BTS, DTS et BUT de biologie appliquée,
- classes préparatoires TB, et ATS post-BTS,
- d'autres formations notamment certaines licences pro,
- INSPÉ (instituts nationaux supérieurs du professorat et de l'éducation) correspondants.
Pour en savoir plus :

Image (c) A.Gaudin, pour UPBM
Enseignement secondaire (lycée)
Préparer mes études supérieures en approfondissant les domaines qui me plaisent, dans une approche concrète et illustrée : "Faire pour comprendre".
Seconde générale et technologique
(Cliquez pour en savoir plus)
Les enseignements technologiques optionnels (ETO) de seconde sont une excellente occasion de découvrir les filières.
Cycle terminal général et technologique
(Touchez pour en savoir plus)
Se préparer à l'enseignement supérieur
Le cycle terminal du lycée général et technologique propose de commencer à se spécialiser dans un domaine, en vue de préparer une poursuite d'études supérieures. La STL comme la ST2S permettent à des élèves curieux et ayant besoin du concret de trouver de quoi nourrir leur projet, et d'accéder à des études supérieures plus sûrement que dans la filière générale, souvent assez théorique.

Enseignement supérieur
Apprendre un métier porteur de sens et de débouchés, pour l'avenir. Construire un parcours progressif en fonction de mes choix et de mes possibilités.

Autres formations
IFSI, etc.
De nombreux autres parcours sont possibles : IFSI, STAPS, université... les parcours restent à inventer par chacun !
Vers le bac+5
Cycle court ou cycle long ?
En fin de cycle court, les étudiants qui ne souhaitent pas s'insérer immédiatement dans la vie professionnelle ont la possibilité de poursuivre leur parcours vers un cycle plus long et accéder au niveau cadre.
Master
Après un cycle court en bac+2, les étudiants qui le souhaitent peuvent poursuivre en L3 puis en Master.
Grandes Écoles
Après la TB naturellement, ou après un BTS éventuellement via une ATS, les étudiants peuvent accéder aux écoles d'ingénieurs du concours "agro" et aux écoles vétérinaires.
Et après ?
Après un master ou après une école d'ingénieur, les étudiants les plus audacieux peuvent réaliser une thèse de troisième cycle universitaire en effectuant des travaux de recherche. D'autres achèvent leurs études médicales.
La majorité cependant s'épanouit déjà en milieu professionnel, en ayant trouvé un emploi en sortie de bac+2, bac+3 ou bac+5.
La majorité cependant s'épanouit déjà en milieu professionnel, en ayant trouvé un emploi en sortie de bac+2, bac+3 ou bac+5.

Insertion professionnelle
Faire ce que j'aime tous les jours, être utile à la société, et trouver du sens dans mon métier.
Les diplômés des formations biotechnologiques profitent de la dynamique des secteurs de débouchés pour s'insérer aisément dans la société : environnement (dépollution, gestion des déchets, biocarburants), alimentation (production, transformation, distribution, restauration), pharmaceutique et cosmétique, santé et soin à la personne, sécurité au travail... leur expertise est partout nécessaire et leur formation complète et de qualité est reconnue et recherchée.
En savoir +
Retrouvez des présentations en vidéos sur nos chaines sociales Dailymotion et YouTube !
Plus de vidéos de présentation sur la playlist correspondante sur notre chaine Dailymotion : Voir sur DailyMotion
Ou sur notre chaine YouTube : Voir sur YouTube